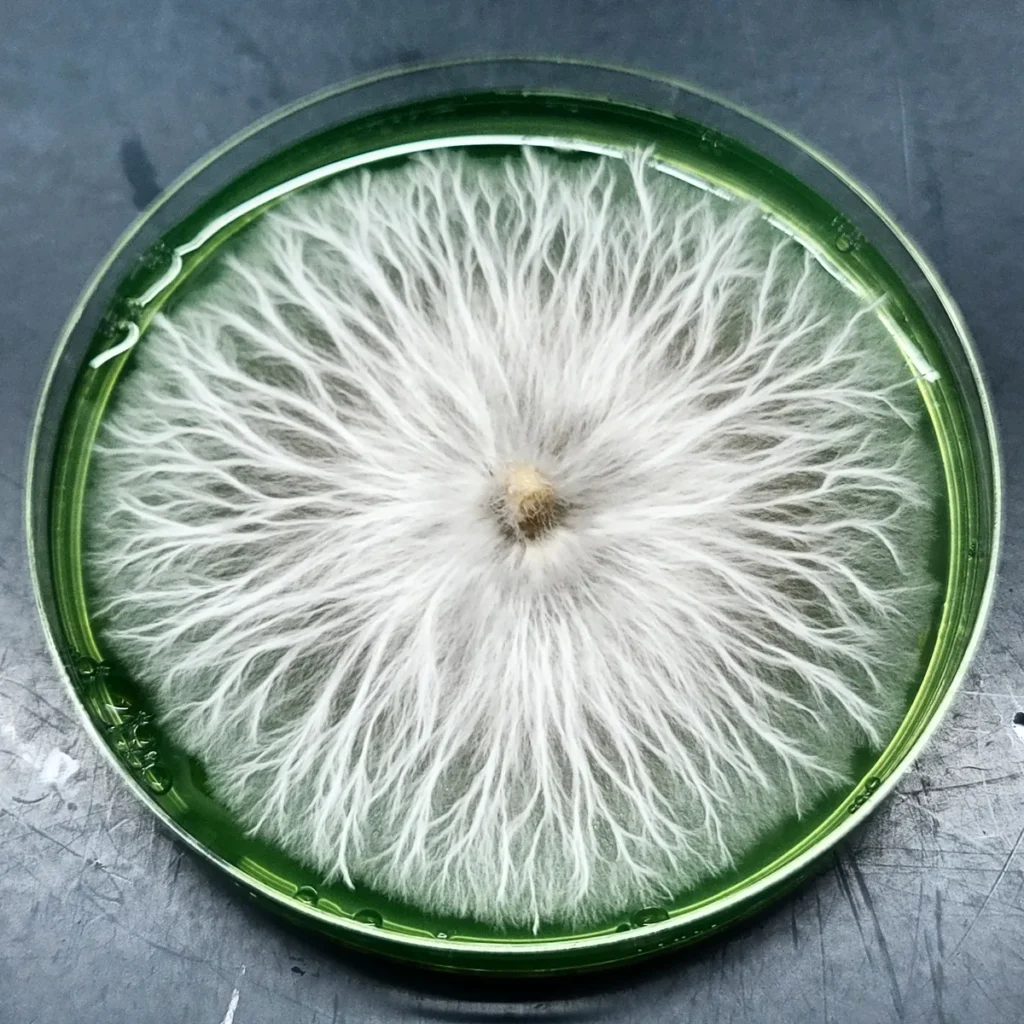

The Best Mushroom Spores for Research: Why Genetic Matters More Than You Think
When most people think of mushrooms, they picture the fruiting bodies we see above ground. You know those familiar caps and stems popping out of the forest floor or a damp log. But anyone who’s spent time studying fungi knows the real magic happens at the microscopic level. Mushroom genetics are the blueprint behind it all: the structure, the resilience, the potency, and even how well a strain adapts to its environment. If you’re searching for the best mushroom spores for research, genetics are where your attention needs to be.

Whether you’re a microscopy enthusiast, a mycology researcher, or a passionate cultivator working with legal species, understanding the genetic makeup of your spores is essential. Good genetics don’t just give you prettier fruiting bodies. They influence everything from growth rates to resistance against contamination and environmental stress. In short, if the genes are strong, the fungi are strong.
That’s where resilience comes in.
What are Resilient Mushroom Genetics?
Resilient mushroom genetics refer to strains that consistently perform well under varying conditions. They’re the strains that don’t cave under pressure—be it temperature shifts, environmental inconsistencies, or long-term storage. They remain viable, stable, and predictable. And this makes them ideal for both scientific study and responsible experimentation.
Why does this matter? Because whether you’re logging microscopy data, observing germination behavior, or even comparing spore morphology between strains, consistency is key. Without a strong genetic foundation, the results can be all over the place. And that’s frustrating for anyone trying to learn or push the science forward.

The thing is, it’s not just about the short term. Strong genetics also mean a longer lifecycle for a strain. When a spore line is resilient, it can be refined and improved over time without losing its integrity. For research and education, that kind of reliability is priceless.
We all all of this to bring ourselves to the big question we’re exploring in this post:
What makes a strong mushroom genetic line?
In the sections ahead, we’ll look at what defines resilient genetics, how they’re developed, and how we ensure quality and consistency here at Basidium Equilibrium. If you care about working with the best spores, this is where it all begins.
What Sets the Best Mushroom Spores for Research Apart?
When it comes to research-grade spores, not all genetics are created equal. The strongest and most resilient spores are defined by more than just what’s visible under a microscope—they’re shaped by the quality of their lineage and the traits they consistently deliver over time. Let’s look at the four biggest factors that make a spore line strong, resilient, and worth your attention.
1. Viability & Spore Health
Healthy spores are the foundation of any meaningful research. Viability refers to the spore’s ability to perform its natural functions—germinate, grow, and express the full range of its genetic traits. Well-preserved spores that are carefully harvested, stored, and handled maintain their vitality longer and offer far more consistent results under the scope.
2. Contamination Resistance
One of the lesser-discussed superpowers of robust genetics is their role in fending off contamination. While clean lab practices are essential, strains with a strong immune profile—so to speak—are less prone to folding under bacterial or mold pressure. This trait is a byproduct of selective refinement over generations.
3. Potency & Stability
For microscopy studies, especially those focused on psilocybin-producing fungi, genetic stability is everything. The best spores come from lines that have been cultivated for consistency—whether you’re observing spore size, structure, or chemical signatures, a stable line offers repeatable, meaningful data. Potency markers also tend to hold strong in these carefully maintained strains.
4. Environmental Adaptability
Fungi are masters of adaptation. Strains that thrive in varied environments—humidity shifts, temperature fluctuations, or diverse substrates—have evolved or been selected for traits that make them resilient under pressure. These are the kinds of genetics you want in your research library.

How Basidium Equilibrium Ensures Genetic Excellence
At Basidium Equilibrium, our passion for mycology drives us to provide the best mushroom spores for research. Our commitment to genetic excellence is evident in our meticulous processes of testing, refining, and maintaining high-quality genetic lines. Here’s how we uphold our standards:
Comprehensive Genetic Mapping
Understanding the lineage and origin of each strain is fundamental. Our Mushroom Origin Map researches and details the history and background of various Psilocybe Cubensis strains. By collecting information from legacy growers, vendors, and genetic experts, we provide dependable data that aids researchers in selecting the most suitable strains for their studies.
Genetic Record Keeping
Our Genetic Vault serves as a meticulously curated collection, unlocking the fascinating world of Psilocybe species and Cubensis varieties. This repository offers in-depth articles, educational resources, and insights into the diverse habitats where these mushrooms flourish. By delving into indigenous traditions and modern research, we bridge the cultural, scientific, and historical dimensions of psilocybin mushrooms, providing a comprehensive understanding for researchers and enthusiasts alike.
Collaborative Preservation
Collaboration is key to preserving genetic integrity. Through our Spore Co-op, we’ve assembled a team of professionals worldwide dedicated to maintaining true genetic lines. With one of the world’s largest Psilocybe herbaria, boasting over 300 Cubensis varieties, our focus is on creating lineage libraries and documenting their histories. This collective effort ensures that valuable genetic information is safeguarded and accessible for future research.
Unwavering Commitment to Quality Control
Quality is at the heart of everything we do. Each strain undergoes rigorous cultivation, testing, and refinement to meet our high standards. Our products are strictly intended for microscopy, research, and novelty purposes, ensuring that researchers receive authentic, high-quality spores. We stand by our genetic cleanliness guarantee, offering replacements if any quality issues arise within 30 days of purchase.

Resilient Genetics Start with Intention
In the world of fungi, strength isn’t just about what you can see—it’s about what’s encoded deep within. As we’ve explored, what makes a strong mushroom genetic line comes down to a blend of resilience, adaptability, and intentional refinement. From spore health and contamination resistance to environmental flexibility and long-term stability, the best mushroom spores for research are built on a solid genetic foundation.
At Basidium Equilibrium, we’re not just selling spores—we’re preserving legacies. Every strain we release carries with it a history, a purpose, and a carefully documented lineage. We believe that when you work with fungi, you’re not just working with nature—you’re participating in a living story that’s still being written.
Whether you’re just beginning your microscopy journey or you’ve been studying mushroom genetics for years, having reliable, research-grade spores makes all the difference. And that’s exactly what we’re here to offer.
Ready to explore the most resilient mushroom genetics available?
Take a look at our full collection of high-quality spores, cultivated for consistency and built for serious research.
Let’s keep pushing the boundaries of what’s possible in mycology—one spore at a time.
You might also be interested in…
-


Carpe Fungum Vintage Mycology Art Tee
$24.95Select options This product has multiple variants. The options may be chosen on the product page












